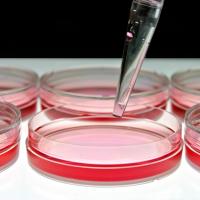

- Andrea Cuscona
Articolo
PALERMO – In Sicilia i medici specialisti convenzionati sono sul sentiero di guerra: con una nota per la stampa è stato comunicato uno sciopero che porterà i camici bianchi a protestare a Palermo davanti all'Assessorato della Salute.
Come si legge nella stessa nota i medici del Coordinamento intersindacale della medicina specialistica... Continua
Articolo
ROMA – Dopo aver analizzato il fenomeno mondiale relativo al “mercato” dei virus giungiamo alla terza ed ultima parte della nostra inchiesta che ci ha visto consultare esperti del settore medico-scientifico, per focalizzare poi l'attenzione sull'epidemiologia. Nei due articoli precedenti ( http://www.ilpapaverorossoweb.it/article/il-%E2%80%... Continua
Articolo
BRUXELLES – Glifosato sì o glifosato no? Su questa delicata scelta si esprimerà a giorni l'Unione Europea: oggetto della discussione è il via libera, fino al 2031, dell'utilizzo della sostanza chimica nei pesticidi. Ad oggi, il glifosato è utilizzato largamente in agricoltura, come erbicida, e sulla sua pericolosità verte il dibattito che sta... Continua
Articolo
ITALIA – Ci siamo: da oggi, martedì 1 marzo 2016, va in pensione la vecchia ricetta medica cartacea ed entra in vigore quella “dematerializzata”, ossia elettronica. Si tratta di un cambiamento epocale nel nostro sistema sanitario nazionale e muterà le abitudini di milioni di italiani, tanto tra i pazienti che usufruiscono del servizio quanto tra i... Continua
Articolo
VENEZIA – Nella giornata odierna in cui si celebra in tutto il Mondo il “Rare Disease Day 2016”, ossia la Giornata delle Malattie Rare (ne abbiamo parlato qui: http://www.ilpapaverorossoweb.it/article/il-%E2%80%9Crare-disease-day%E2%80%9D-dare-voce-alle-malattie-rare), abbiamo avuto il piacere di intervistare Renza Barbon Galluppi, presidente... Continua
Articolo
ITALIA/MONDO – Di per sé il 29 febbraio è un giorno molto particolare: siamo, infatti, in anno bisestile e il mese di febbraio, in questo 2016, conterà un giorno in più. Se ne riparlerà tra quattro anni. Certo, questa è solo una coincidenza ma a rendere speciale ogni ultimo giorno di febbraio, da nove anni a questa parte, è la celebrazione del “... Continua
Articolo
INDIA - Dall'Oriente asiatico sembra arrivare una prima ma significativa esperienza concreta di sviluppo dell'agricoltura 100% bio. Il piccolo stato del Sikkim, che si trova nell'estremità nord-orientale del sub-continente indiano, al confine con la Cina e tra Nepal e Bhutan, ha infatti intrapreso, da alcuni anni, una politica molto precisa in... Continua
Articolo
ROMA – Nella scorsa “puntata” della nostra inchiesta sul mercato mondiale dei virus abbiamo accennato all'indagine condotta prima negli USA e poi sviluppatasi anche in Italia. Da lì abbiamo tratto spunto per tracciare il percorso, legale, che seguono i virus per giungere nel nostro paese: ATCC, una delle aziende leader a livello mondiale nella... Continua
Articolo
ROMA – È possibile acquistare liberamente virus? Pare proprio di sì. Quel che raccontiamo in questo nostro servizio può sembrare quasi assurdo e abbiamo deciso, dunque, di approfondire l'argomento. Tutto trae origine da un episodio di cronaca tornato alla ribalta recentemente.
Bisogna, però, tornare indietro di qualche anno, quando una lunga... Continua
Articolo
ROMA - Basta una semplice osservazione quotidiana, da “profani”, per capire che il clima sta mutando, molto velocemente. Alle nostre latitudini assistiamo a fenomeni atmosferici di grande portata e sempre più distribuiti in maniera anomala dell'arco dei 12 mesi, senza che si possano più rintracciare davvero le stagioni e le loro peculiarità. Che... Continua